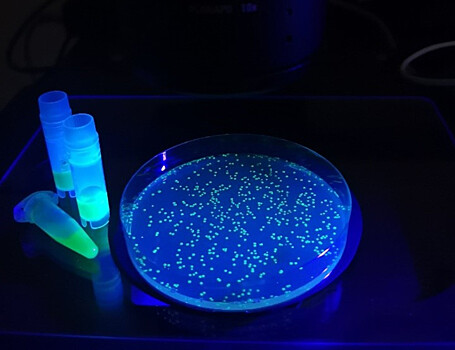
Разработан биосенсор для отслеживания процессов воспаления
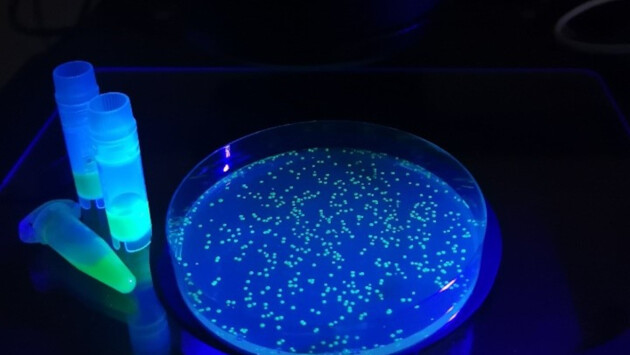

Разработан биосенсор для отслеживания процессов воспаления
Российские ученые из Института биоорганической химии совместно с другими отечественными и зарубежными институтами разработали светящийся биосенсор, который поможет отслеживать динамику гипогалогенных кислот. Их выработка в организме связана с воспалительными процессами в тканях. Научная статья о проделанной работе опубликована в журнале Nature Communications.Когда в организм попадают вредоносные микробы или повреждаются ткани, иммунная система запускает процесс воспаления. На защиту выходят специальные клетки — нейтрофилы и макрофаги. Их главная функция — поглощать и нейтрализовать патогены и продукты распада тканей организма. Для этого иммунные клетки вырабатывают особые химические соединения. Так, они производят активные формы хлора, к которым относится агрессивный гипохлорит-анион. Он обладает высокой реакционной способностью. Иммунные клетки производят и другие соединения с аналогичными свойствами. Вместе их называют гипогалогенными кислотами. Фермент, который отвечает за их образование, содержится в дыхательных путях, в ротовой полости, в грудном молоке и даже в слезах человека. Несмотря на то что обычно гипогалогенные кислоты вырабатываются для защиты организма, иногда они могут вызвать стресс у клеток организма. Таким образом иммунная система может ошибочно повредить ткани организма.Российские ученые придумали биосенсор Hypocrates, который отслеживает динамику гипогалогенных кислот в тканях. Благодаря ему можно понять, происходит ли гипогалогенный стресс, или нет. Этот биосенсор, по сути, представляет собой белковую молекулу, состоящую из двух фрагментов. Один из них является непосредственно сенсором: он вступает в специфическую реакцию с гипогалогенными кислотами. Второй фрагмент флуоресцирует, то есть светится. Следовательно, интенсивность свечения изменяется в зависимости от содержания гипогалогенных кислот в тканях. Что интересно, этот биосенсор закодирован генетически, поэтому с помощью средств генной инженерии он может быть доставлен в любые клетки.Сенсор Hypocrates уже был протестирован на живых организмах. При введении гена, кодирующего биосенсор, в организм рыб данио-рерио ученые смогли одновременно продемонстрировать оксидативный и гипогалогенный стресс в клетках рыб в динамике. Такая визуализация была сделана впервые в мире. Кроме того, исследователи показали гипогалогенный стресс в бактериях, поглощенных нейтрофилами человека. Оба этих эксперимента показали, что биосенсор работает и, следовательно, готов к медицинским исследованиям.«Большинство патологических процессов сопровождается развитием воспалительных реакций. Поэтому создание новых инструментов для исследований в этой области имеет важное значение не только для понимания механизмов в основе того или иного заболевания, но и для разработок терапии лечения. Кроме того, наш инструмент интересен для поиска новых физиологических функций гипогалогенных кислот и их производных», — заключил Дмитрий Билан, кандидат биологических наук, руководитель группы метаболических основ патологии ИБХ РАН и глава проекта.Подписывайтесь на InScience.News в социальных сетях: ВКонтакте, Telegram, Facebook и Twitter.